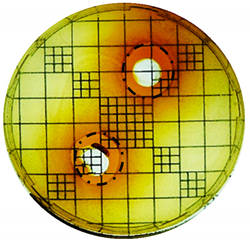
Cosmetics 06 00030 i003

Effects of a Phenol-Enriched Purified Extract from Olive Mill Wastewater on Skin Cells
Abstract
:1. Introduction
2. Materials and Methods
2.1. Preparation of the Olive Mill Wastewater (OMWW)
2.2. Cell Viability Assay
2.3. Anti-Inflammatory Assay In Vitro
2.4. Assessment of the Antimicrobial Properties
2.5. Reactive Oxygen Species (ROS) Assay In Vitro
2.6. Tumor Invasion in a Full-Thickness Skin Model In Vitro
2.7. Data Analysis and Statistics
3. Results
3.1. Phenol-Enriched OMWW Extract Reduces Interleukin-8 Release in Epidermal Skin Cells (In Vitro)
3.2. Phenol-Enriched OMWW Extract Inhibits the Growth of Selected Pathogenic Skin Organism
3.3. Phenol-Enriched OMWW Extract Reduce the Formation of Free Radicals In Vitro
3.4. The Phenol-Enriched OMWW Extract Modulates the Invasion of Tumor Cells in the Skin In Vitro
4. Discussion
5. Conclusions
Author Contributions
Funding
Acknowledgments
Conflicts of Interest
References
- Psaltopoulou, T.; Kosti, R.I.; Haidopoulos, D.; Dimopoulos, M.; Panagiotakos, D.B. Olive oil intake is inversely related to cancer prevalence: A systematic review and a meta-analysis of 13800 patients and 23340 controls in 19 observational studies. Lipids Health Dis. 2011, 10, 127. [Google Scholar] [CrossRef] [PubMed]
- Barbaro, B.; Toietta, G.; Maggio, R.; Arciello, M.; Tarocchi, M.; Galli, A.; Balsano, C. Effects of the olive-derived polyphenol oleuropein on human health. Int. J. Mol. Sci. 2014, 15, 18508–18524. [Google Scholar] [CrossRef] [PubMed]
- Bisignano, G.; Tomaino, A.; Cascio, R.L.; Crisafi, G.; Uccella, N.; Saija, A. On the in-vitro antimicrobial activity of oleuropein and hydroxytyrosol. J. Pharm. Pharmacol. 1999, 51, 971–974. [Google Scholar] [CrossRef]
- Caporaso, N.; Formisano, D.; Genovese, A. Use of phenolic compounds from olive mill wastewater as valuable ingredients for functional foods. Crit. Rev. Food Sci. Nutr. 2018, 58, 2829–2841. [Google Scholar] [CrossRef] [PubMed]
- Cicerale, S.; Lucas, L.; Keast, R. Biological activities of phenolic compounds present in virgin olive oil. Int. J. Mol. Sci. 2010, 11, 458–479. [Google Scholar] [CrossRef]
- Souilem, S.; El-Abbassi, A.; Kiai, H.; Hafidi, A.; Sayadi, S.; Galanakis, C.M. Olive oil production sector: Environmental effects and sustainability challenges. Olive Mill Waste 2017. [Google Scholar] [CrossRef]
- Mulinacci, N.; Romani, A.; Galardi, C.; Pinelli, P.; Giaccherini, C.; Vincieri, F.F. Polyphenolic content in olive oil waste waters and related olive samples. J. Agric. Food Chem. 2001, 49, 3509–3514. [Google Scholar] [CrossRef]
- Frankel, E.; Bakhouche, A.; Lozano-Sánchez, J.S.; Segura-Carretero, A.; Fernández-Gutiérrez, A. Literature review on production process to obtain extra virgin olive oil enriched in bioactive compounds. Potential use of byproducts as alternative sources of polyphenols. J. Agric. Food Chem. 2013, 61, 5179–5188. [Google Scholar] [CrossRef]
- Ambriz-Pérez, D.L.; Leyva-López, N.; Gutierrez-Grijalva, E.P.; Heredia, J.B. Phenolic compounds: Natural alternative in inflammation treatment. A Review. Cogent Food Agric. 2016, 2, 1131412. [Google Scholar]
- Daglia, M. Polyphenols as antimicrobial agents. Curr. Opin. Biotechnol. 2012, 23, 174–181. [Google Scholar] [CrossRef]
- Raederstorff, D. Antioxidant activity of olive polyphenols in humans: A review. Int. J. Vitam. Nutr. Res. 2009, 79, 152–165. [Google Scholar] [CrossRef] [PubMed]
- Bassani, B.; Rossi, T.; Stefano, D.D.; Pizzichini, D.; Corradino, P.; Macrì, N.; Noonan, D.M.; Albini, A.; Bruno, A. Potential chemopreventive activities of a polyphenol rich purified extract from olive mill wastewater on colon cancer cells. J. Funct. Foods 2016, 27, 236–248. [Google Scholar] [CrossRef]
- Di Mauro, M.D.; Tomasello, B.; Giardina, R.C.; Dattilo, S.; Mazzei, V.; Sinatra, F.; Caruso, M.; D’Antona, N.; Renis, M. Sugar and mineral enriched fraction from olive mill wastewater for promising cosmeceutical application: Characterization, in vitro and in vivo studies. Food Funct. 2017, 8, 4713–4722. [Google Scholar] [CrossRef]
- Rossi, T.; Bassani, B.; Gallo, C.; Maramotti, S.; Noonan, D.; Albini, A.; Bruno, A. Effect of a purified extract of olive mill waste water on endothelial cell proliferation, apoptosis, migration and capillary-like structure in vitro and in vivo. J. Bioanal. Biomed. 2015, 12, 006. [Google Scholar]
- Europäisches Arzneibuch (Pharmacopeia Europaea). 5.1.3 Prüfung auf Ausreichende Antimikrobielle Konservierung; Ausgabe, Grundwerk 2017; Deutscher Apotheker Verlag: Stuttgart, Germany, 2017; Volume 9. [Google Scholar]
- Sun, T.; Jackson, S.; Haycock, J.W.; MacNeil, S. Culture of skin cells in 3D rather than 2D improves their ability to survive exposure to cytotoxic agents. J. Biotechnol. 2006, 122, 372–381. [Google Scholar] [CrossRef] [PubMed]
- Ravi, M.; Paramesh, V.; Kaviya, S.R.; Anuradha, E.; Solomon, F.D. 3D cell culture systems: Advantages and applications. J. Cell. Physiol. 2015, 230, 16–26. [Google Scholar] [CrossRef]
- Obied, H.K.; Prenzler, P.D.; Omar, S.H.; Ismael, R.; Servili, M.; Esposto, S.; Taticchi, A.; Selvaggini, R.; Urbani, S. Pharmacology of olive biophenols. In Advances in Molecular Toxicology; Elsevier: Amsterdam, The Netherlands, 2012; pp. 195–242. [Google Scholar]
- Mahmoudi, S.; Khali, M.; Benkhaled, A.; Benamirouche, K.; Baiti, I. Phenolic and flavonoid contents, antioxidant and antimicrobial activities of leaf extracts from ten Algerian Ficus carica L. varieties. Asian Pac. J. Trop. Biomed. 2016, 6, 239–245. [Google Scholar] [CrossRef]
- Visioli, F.; Bellomo, G.; Galli, C. Free radical-scavenging properties of olive oil polyphenols. Biochem. Biophys. Res. Commun. 1998, 247, 60–64. [Google Scholar] [CrossRef]
- Mast, B.A.; Schultz, G.S. Interactions of cytokines, growth factors, and proteases in acute and chronic wounds. Wound Repair Regen. 1996, 4, 411–420. [Google Scholar] [CrossRef]
- Fabiani, R.; de Bartolomeo, A.; Rosignoli, P.; Servili, M.; Selvaggini, R.; Montedoro, G.F.; di Saverio, C.; Morozzi, G. Virgin olive oil phenols inhibit proliferation of human promyelocytic leukemia cells (HL60) by inducing apoptosis and differentiation. J. Nutr. 2006, 136, 614–619. [Google Scholar] [CrossRef]
- Sirianni, R.; Chimento, A.; Luca, A.d.; Casaburi, I.; Rizza, P.; Onofrio, A.; Iacopetta, D.; Puoci, F.; Andò, S.; Maggiolini, M. Oleuropein and hydroxytyrosol inhibit MCF-7 breast cancer cell proliferation interfering with ERK1/2 activation. Mol. Nutr. Food Res. 2010, 54, 833–840. [Google Scholar] [CrossRef]
- Nichenametla, S.N.; Taruscio, T.G.; Barney, D.L.; Exon, J.H. A Review of the Effects and Mechanisms of Polyphenolics in Cancer. Crit. Rev. Food Sci. Nutr. 2006, 46, 161–183. [Google Scholar] [CrossRef]
- Klausner, M.; Kaluzhny, Y.; Ayehunie, S. Reconstructed human skin model to study melanoma at different stages of progression. J. Investig. Dermatol. 2011, 131, 75. [Google Scholar]
- Halder, B.; Bhattacharya, U.; Mukhopadhyay, S.; Giri, A. Molecular mechanism of black tea polyphenols induced apoptosis in human skin cancer cells: Involvement of Bax translocation and mitochondria mediated death cascade. Carcinogenesis 2008, 29, 129–138. [Google Scholar] [CrossRef] [PubMed]
- Ahmad, N.; Feyes, D.K.; Nieminen, A.L.; Agarwal, R.; Mukhtar, H. Green tea constituent epigallocatechin-3-gallate and induction of apoptosis and cell cycle arrest in human carcinoma cells. J. Natl. Cancer Inst. 1997, 89, 1881–1886. [Google Scholar] [CrossRef]
- Imran, M.; Nadeem, M.; Gilani, S.A.; Khan, S.; Sajid, M.W.; Amir, R.M. Antitumor Perspectives of Oleuropein and Its Metabolite Hydroxytyrosol: Recent Updates. J. Food Sci. 2018, 83, 1781–1791. [Google Scholar] [CrossRef] [PubMed]
- Carrera-González, M.; Ramírez-Expósito, M.J.; Mayas, M.; Martínez-Martos, J.M. Protective role of oleuropein and its metabolite hydroxytyrosol on cancer. Trends Food Sci. Technol. 2013, 31, 92–99. [Google Scholar] [CrossRef]







| Phenolic Ingredient | Concentration/g·L−1 |
|---|---|
| hydroxytyrosol glycoside | 2.01 |
| hydroxytyrosol | 2.52 |
| tyrosol and derivates of glycosids | 0.80 |
| chlorogenic acid | 0.10 |
| caffeic acid | n.d. |
| β-hydroxy-verbascoside isomer 1 | 0.29 |
| β-hydroxy-verbascoside isomer 2 | 0.26 |
| rutin | n.d. |
| Verbascoside | 1.04 |
| luteolin-7-glucoside | n.d. |
| nüzhenide | n.d. |
| Isoverbascoside | n.d. |
| 3,4-DHPEA-EDA (oleacein) | n.d. |
| oleuropein aglycon | 0.71 |
| p-coumaroyl-secologanoside | 0.38 |
| Oleocanthal | not analyzed |
| total absorption (280 nm) | 14.67 |
| Test Organism, Strain ID | Broth |
|---|---|
| Staphylococcus aureus, WDCM 00035 | Casein soya peptone agar |
| Escherichia coli, DSMZ 301 | Casein soya peptone agar |
| Pseudomonas aeruginosa, WDCM 00026 | Casein soya peptone agar |
| Candida albicans, WDCM 00054 | Sabouraud dextrose agar without antibiotic supplements |
| Aspergillus brasiliensis, WDCM 00053 | Sabouraud dextrose agar without antibiotic supplements |
| Staphylococcus epidermidis, WDCM 00036 | Casein soya peptone agar |
| Propionibacterium acnes, DSMZ 1897 | Casein soya peptone agar |
| Test Organism | CFU/g (Start) | 2 d | 7 d | ||
|---|---|---|---|---|---|
| CFU/g Sample | Reduction in % | CFU/g Sample | Reduction in % | ||
| S. aureus | 4.30 × 105 | <10 | >99.99 | <10 | >99.99 |
| E. coli | 1.06 × 106 | <10 | >99.99 | <10 | >99.99 |
| P. aeruginosa | 8.70 × 105 | <10 | >99.99 | <10 | >99.99 |
| C. albicans | 3.20 × 105 | <10 | >99.99 | <10 | >99.99 |
| A. brasiliensis | 8.00 × 104 | 3500 | 95.63 | not determined | not determined |
| S. epidermidis | 1.16 × 106 | <10 | >99.99 | <10 | >99.99 |
| P. acnes | 1.20 × 106 | <10 | >99.99 | <10 | >99.99 |
| Punch Hole Method | Paper Disk Method | |
|---|---|---|
| S. aureus: |  |  |
| E. coli: | |  |
| P. aeruginosa: |  |  |
| C. albicans: |  |  |
| A. brasiliensis: |  |  |
| S.epidermidis: |  |  |
| P. acnes: |  |  |
| Organism | Inoculation CFU/g Sample | Inhibition Zone/mm (Punch Hole Method) | Inhibition Zone/mm (Paper Disc Method) |
|---|---|---|---|
| S. aureus | 4.30 × 106 | 3.0 | 2.0 |
| E. coli | 1.06 × 107 | 4.0 | 2.5 |
| P. aeruginosa | 8.70 × 106 | 3.5 | 3.0 |
| C. albicans | 3.20 × 106 | 0 | 0 |
| A. brasiliensis | 8.00 × 105 | 0 | 0 |
| S. epidermidis | 1.16 × 107 | 7.0 | 3.1 |
| P. acnes | 1.20 × 106 | 9.0 | 7.0 |
© 2019 by the authors. Licensee MDPI, Basel, Switzerland. This article is an open access article distributed under the terms and conditions of the Creative Commons Attribution (CC BY) license (http://creativecommons.org/licenses/by/4.0/).
Share and Cite
Schlupp, P.; Schmidts, T.M.; Pössl, A.; Wildenhain, S.; Lo Franco, G.; Lo Franco, A.; Lo Franco, B. Effects of a Phenol-Enriched Purified Extract from Olive Mill Wastewater on Skin Cells. Cosmetics 2019, 6, 30. https://doi.org/10.3390/cosmetics6020030
Schlupp P, Schmidts TM, Pössl A, Wildenhain S, Lo Franco G, Lo Franco A, Lo Franco B. Effects of a Phenol-Enriched Purified Extract from Olive Mill Wastewater on Skin Cells. Cosmetics. 2019; 6(2):30. https://doi.org/10.3390/cosmetics6020030
Chicago/Turabian StyleSchlupp, Peggy, Thomas M. Schmidts, Axel Pössl, Sören Wildenhain, Gianni Lo Franco, Antonio Lo Franco, and Bandino Lo Franco. 2019. "Effects of a Phenol-Enriched Purified Extract from Olive Mill Wastewater on Skin Cells" Cosmetics 6, no. 2: 30. https://doi.org/10.3390/cosmetics6020030
APA StyleSchlupp, P., Schmidts, T. M., Pössl, A., Wildenhain, S., Lo Franco, G., Lo Franco, A., & Lo Franco, B. (2019). Effects of a Phenol-Enriched Purified Extract from Olive Mill Wastewater on Skin Cells. Cosmetics, 6(2), 30. https://doi.org/10.3390/cosmetics6020030




